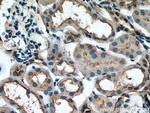
PARD6B Antibody in Immunohistochemistry (Paraffin) (IHC (P))

Search
Proteintech
PARD6B Polyclonal Antibody
{{$productOrderCtrl.translations['antibody.pdp.commerceCard.promotion.promotions']}}
{{$productOrderCtrl.translations['antibody.pdp.commerceCard.promotion.viewpromo']}}
{{$productOrderCtrl.translations['antibody.pdp.commerceCard.promotion.promocode']}}: {{promo.promoCode}} {{promo.promoTitle}} {{promo.promoDescription}}. {{$productOrderCtrl.translations['antibody.pdp.commerceCard.promotion.learnmore']}}
产品信息
13996-1-AP
种属反应
宿主/亚型
分类
类型
抗原
偶联物
形式
浓度
规格
纯化类型
保存液
内含物
保存条件
运输条件
产品详细信息
This antibody detects PARD6B with an apparent molecular weight of 50-53 kDa as has been demonstrated by several researches.
Immunogen sequence: MNRSHRHGA GSGCLGTMEV KSKFGAEFRR FSLERSKPGK FEEFYGLLQH VHKIPNVDVL VGYADIHGDL LPINNDDNYH KAVSTANPLL RIFIQKKEEA DYSAFGTDTL IKKKNVLTNV LRPDNHRKKP HIVISMPQDF RPVSSIIDVD ILPETHRRVR LYKYGTEKPL GFYIRDGSSV RVTPHGLEKV PGIFISRLVP GGLAQSTGLL AVNDEVLEVN GIEVSGKSLD QVTDMMIANS RNLIITVRPA NQRNNVVRNS RTSGSSGQST DNSLLGYPQQ IEPSFEPEDE DSEEDDIIIE DNGVPQQIPK AVPNTESLES LTQIELSFES GQNGFIPSNE VSLAAIASSS NTEFETHAPD QKLLEEDGTI ITL (1-372 aa encoded by BC060847)
靶标信息
This gene is a member of the PAR6 family and encodes a protein with a PSD95/Discs-large/ZO1 (PDZ) domain, an OPR domain and a semi-Cdc42/Rac interactive binding (CRIB) domain. This cytoplasmic protein is involved in asymmetrical cell division and cell polarization processes as a member of a multi-protein complex.
仅用于科研。不用于诊断过程。未经明确授权不得转售。
生物信息学
蛋白别名: par-6 (partitioning defective 6) homolog beta; PAR-6 beta; par-6 partitioning defective 6 homolog beta; PAR-6B; Partitioning defective 6 homolog beta; partitioning-defective protein 6, beta
基因别名: AV025615; PAR6B; PARD6B
UniProt ID: (Human) Q9BYG5, (Mouse) Q9JK83
Entrez Gene ID: (Human) 84612, (Mouse) 58220, (Rat) 362279